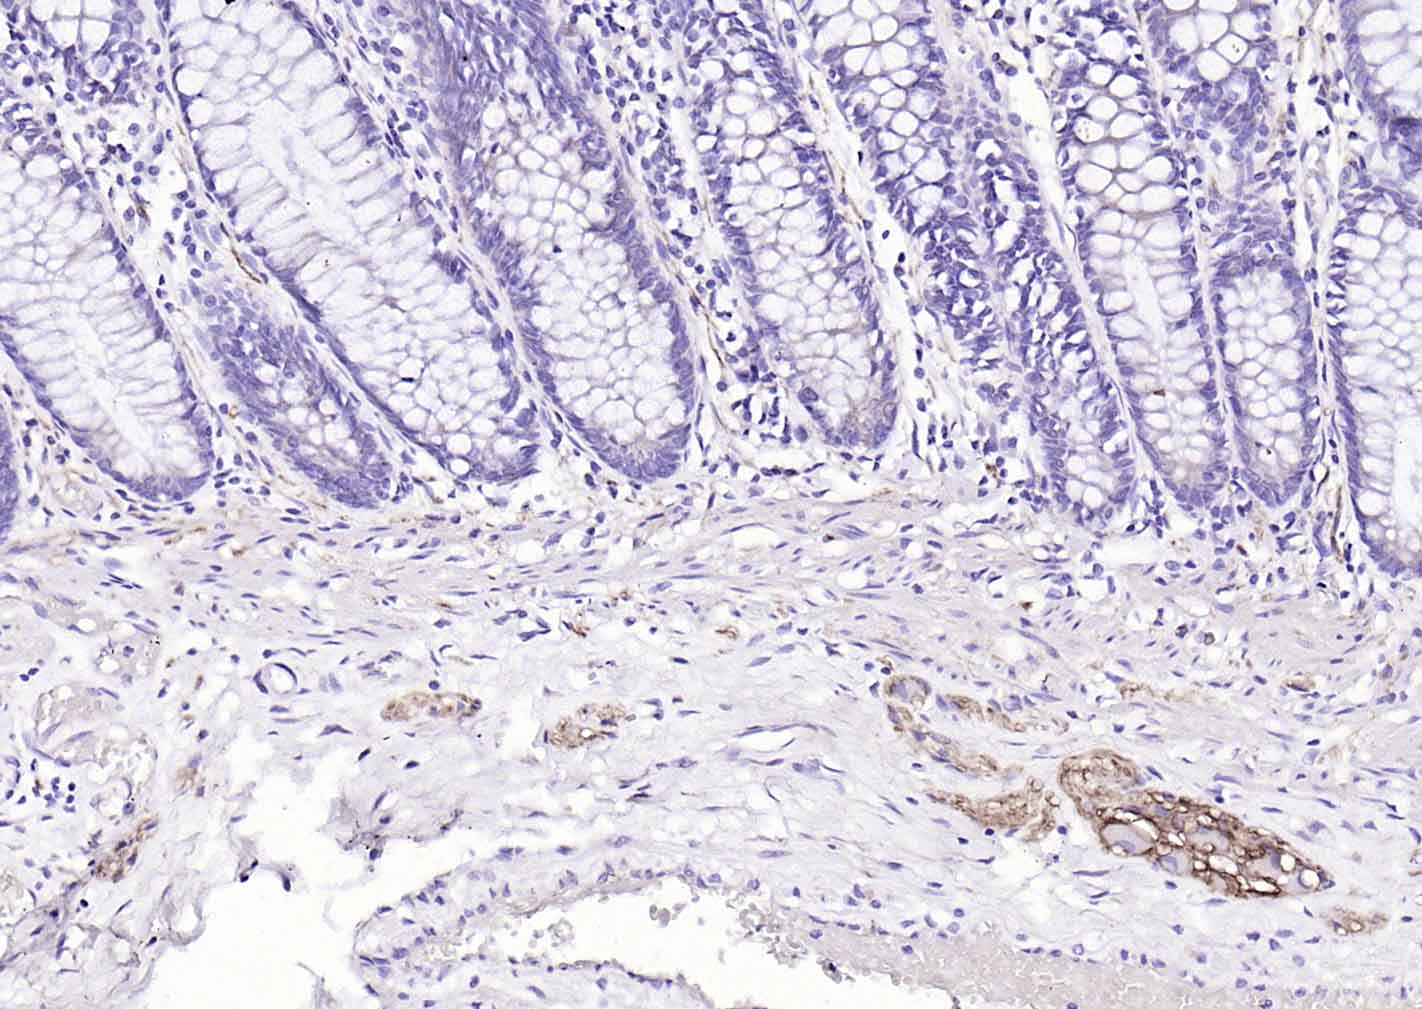
产品细节图片5

相关产品推荐更多 >
万千商家帮你免费找货
0 人在求购买到急需产品
- 详细信息
- 文献和实验
- 技术资料
- 应用范围:
产品信息以Bioss网站为准
- 规格:
50ul/100ul/25ul
| 规格: | 50ul | 产品价格: | ¥1400.0 |
|---|---|---|---|
| 规格: | 100ul | 产品价格: | ¥2500.0 |
| 规格: | 25ul | 产品价格: | ¥800.0 |
| 产品编号 | bsm-52824R |
| 英文名称 | NCAM Recombinant Rabbit mAb |
| 中文名称 | 神经细胞粘附分子1重组兔单抗 |
| 英文别名 | CD56 antigen; Cell Adhesion Molecule Neural 1; MSK39; N CAM 120; N CAM 140; N CAM 180; NCAM 1; NCAM 120; NCAM 140; NCAM1; Neural cell adhesion molecule 1 120 kDa isoform; Neural cell adhesion molecule 1 140 kDa isoform; Neural cell adhesion molecule 1; NCAM1_HUMAN. |
| 产品应用 | IHC-P=1:100-500, IHC-F=1:100-500, ICC/IF=1:50-200, IF=1:100-500 Not yet tested in other applications. |
| 交叉反应 | Human, Mouse (Rat) |
| 抗体来源 | Rabbit |
| 免疫原 | KLH conjugated synthetic peptide derived from human NCAM |
| 亚型 | IgG |
| 性状 | Liquid |
| 纯化方法 | affinity purified by Protein A |
| 克隆类型 | Recombinant |
| 理论分子量 | 92 kDa |
| 浓度 | 1mg/ml |
| 储存液 | 0.01M TBS (pH7.4) with 1% BSA, 0.02% Proclin300 and 50% Glycerol. |
| 研究领域 | Neuroscience > Cell Adhesion Proteins > ECM Proteins Neuroscience > Cell Type Marker > Neuron marker > Growth Cone Neuroscience > Neurology process > Neural Signal Transduction Stem Cells > Hematopoietic Progenitors > Hematopoietic Stem Cells > Human Lineage Negative |
| 亚细胞定位 | Isoform 1, 2,: Cell membrane; Single-pass type I membrane protein. Isoform 3, 4: Cell membrane; Lipid-anchor, GPI-anchor. Isoform 5, 6: Secreted. |
| 相似性 | Contains 2 fibronectin type-III domains. Contains 5 Ig-like C2-type (immunoglobulin-like) domains. |
| 功能 | This protein is a cell adhesion molecule involved in neuron-neuron adhesion, neurite fasciculation, outgrowth of neurites, etc. Subcellular Location : Isoform 1, 2,: Cell membrane; Single-pass type I membrane protein. Isoform 3, 4: Cell membrane; Lipid-anchor, GPI-anchor. Isoform 5, 6: Secreted. |
| 保存条件 | Shipped at 4℃. Store at -20℃ for one year. Avoid repeated freeze/thaw cycles. |
| 注意事项 | This product as supplied is intended for research use only, not for use in human, therapeutic or diagnostic applications. |
| 背景资料 | This gene encodes a cell adhesion protein which is a member of the immunoglobulin superfamily. The encoded protein is involved in cell-to-cell interactions as well as cell-matrix interactions during development and differentiation. The encoded protein has been shown to be involved in development of the nervous system, and for cells involved in the expansion of T cells and dendritic cells which play an important role in immune surveillance. Alternative splicing results in multiple transcript variants. [provided by RefSeq, Jun 2011] |
| 应用 | 推荐稀释比例 |
| {IHC-P} | {1:100-500} |
| {IHC-F} | {1:100-500} |
| {ICC/IF} | {1:50-200} |
| {IF} | {1:100-500} |

风险提示:丁香通仅作为第三方平台,为商家信息发布提供平台空间。用户咨询产品时请注意保护个人信息及财产安全,合理判断,谨慎选购商品,商家和用户对交易行为负责。对于医疗器械类产品,请先查证核实企业经营资质和医疗器械产品注册证情况。
文献和实验[IF={{ 9.429 }}] {Zhang Yufan. et al. Scalable and high-throughput production of an injectable platelet-rich plasma (PRP)/cell-laden microcarrier/hydrogel composite system for hair follicle tissue engineering. J NANOBIOTECHNOL. 2022 Dec;20(1):1-22} {WB} {Mouse}
到 PVDF 膜上,同时减少蛋白不必要降解,这对于最终获得清晰、可信结果也是需要考虑因素。抗体信息:1.ACC1, Recombinant Rabbit monoclonal IgG. HuaAn. HuaAn biotechnology , inc.2.ATGL, Mouse mAb IgG1, Cat#:RT1058. HuaAn biotechnology , inc.3.p-PERK(Thr981), Rabbit Polyclonal IgG primary antibodies, Cat
The OP9-DL1 System: Generation of T-Lymphocytes from Embryonic or Hematopoietic Stem Cells In Vitro
al. 2006b ). MATERIALS Reagents Anti-CD24 monoclonal antibody (mAb) (J11d clone) (for Protocol 3) Use either culture supernatant that contains anti-CD24 mAb or purified anti-CD24 mAb (see Step 55). BDPharmLyse (red blood cell lysing
【资源】全面归类网址:毕赤酵母表达各种来源蛋白(细菌,真菌,植物,人类等)
, 12 mg/L, α-MF or endogenous signal507Porcine pepsinogenS, PHO, 30 mg/L, active504Rabbit intestinal peptide transporter (PepT1)I[177]Rabbit intestinal peptide transporter (PEPT2)I[178]Rabbit antibody: monoclonal single-chain Fv specific for recombinant
技术资料暂无技术资料 索取技术资料








